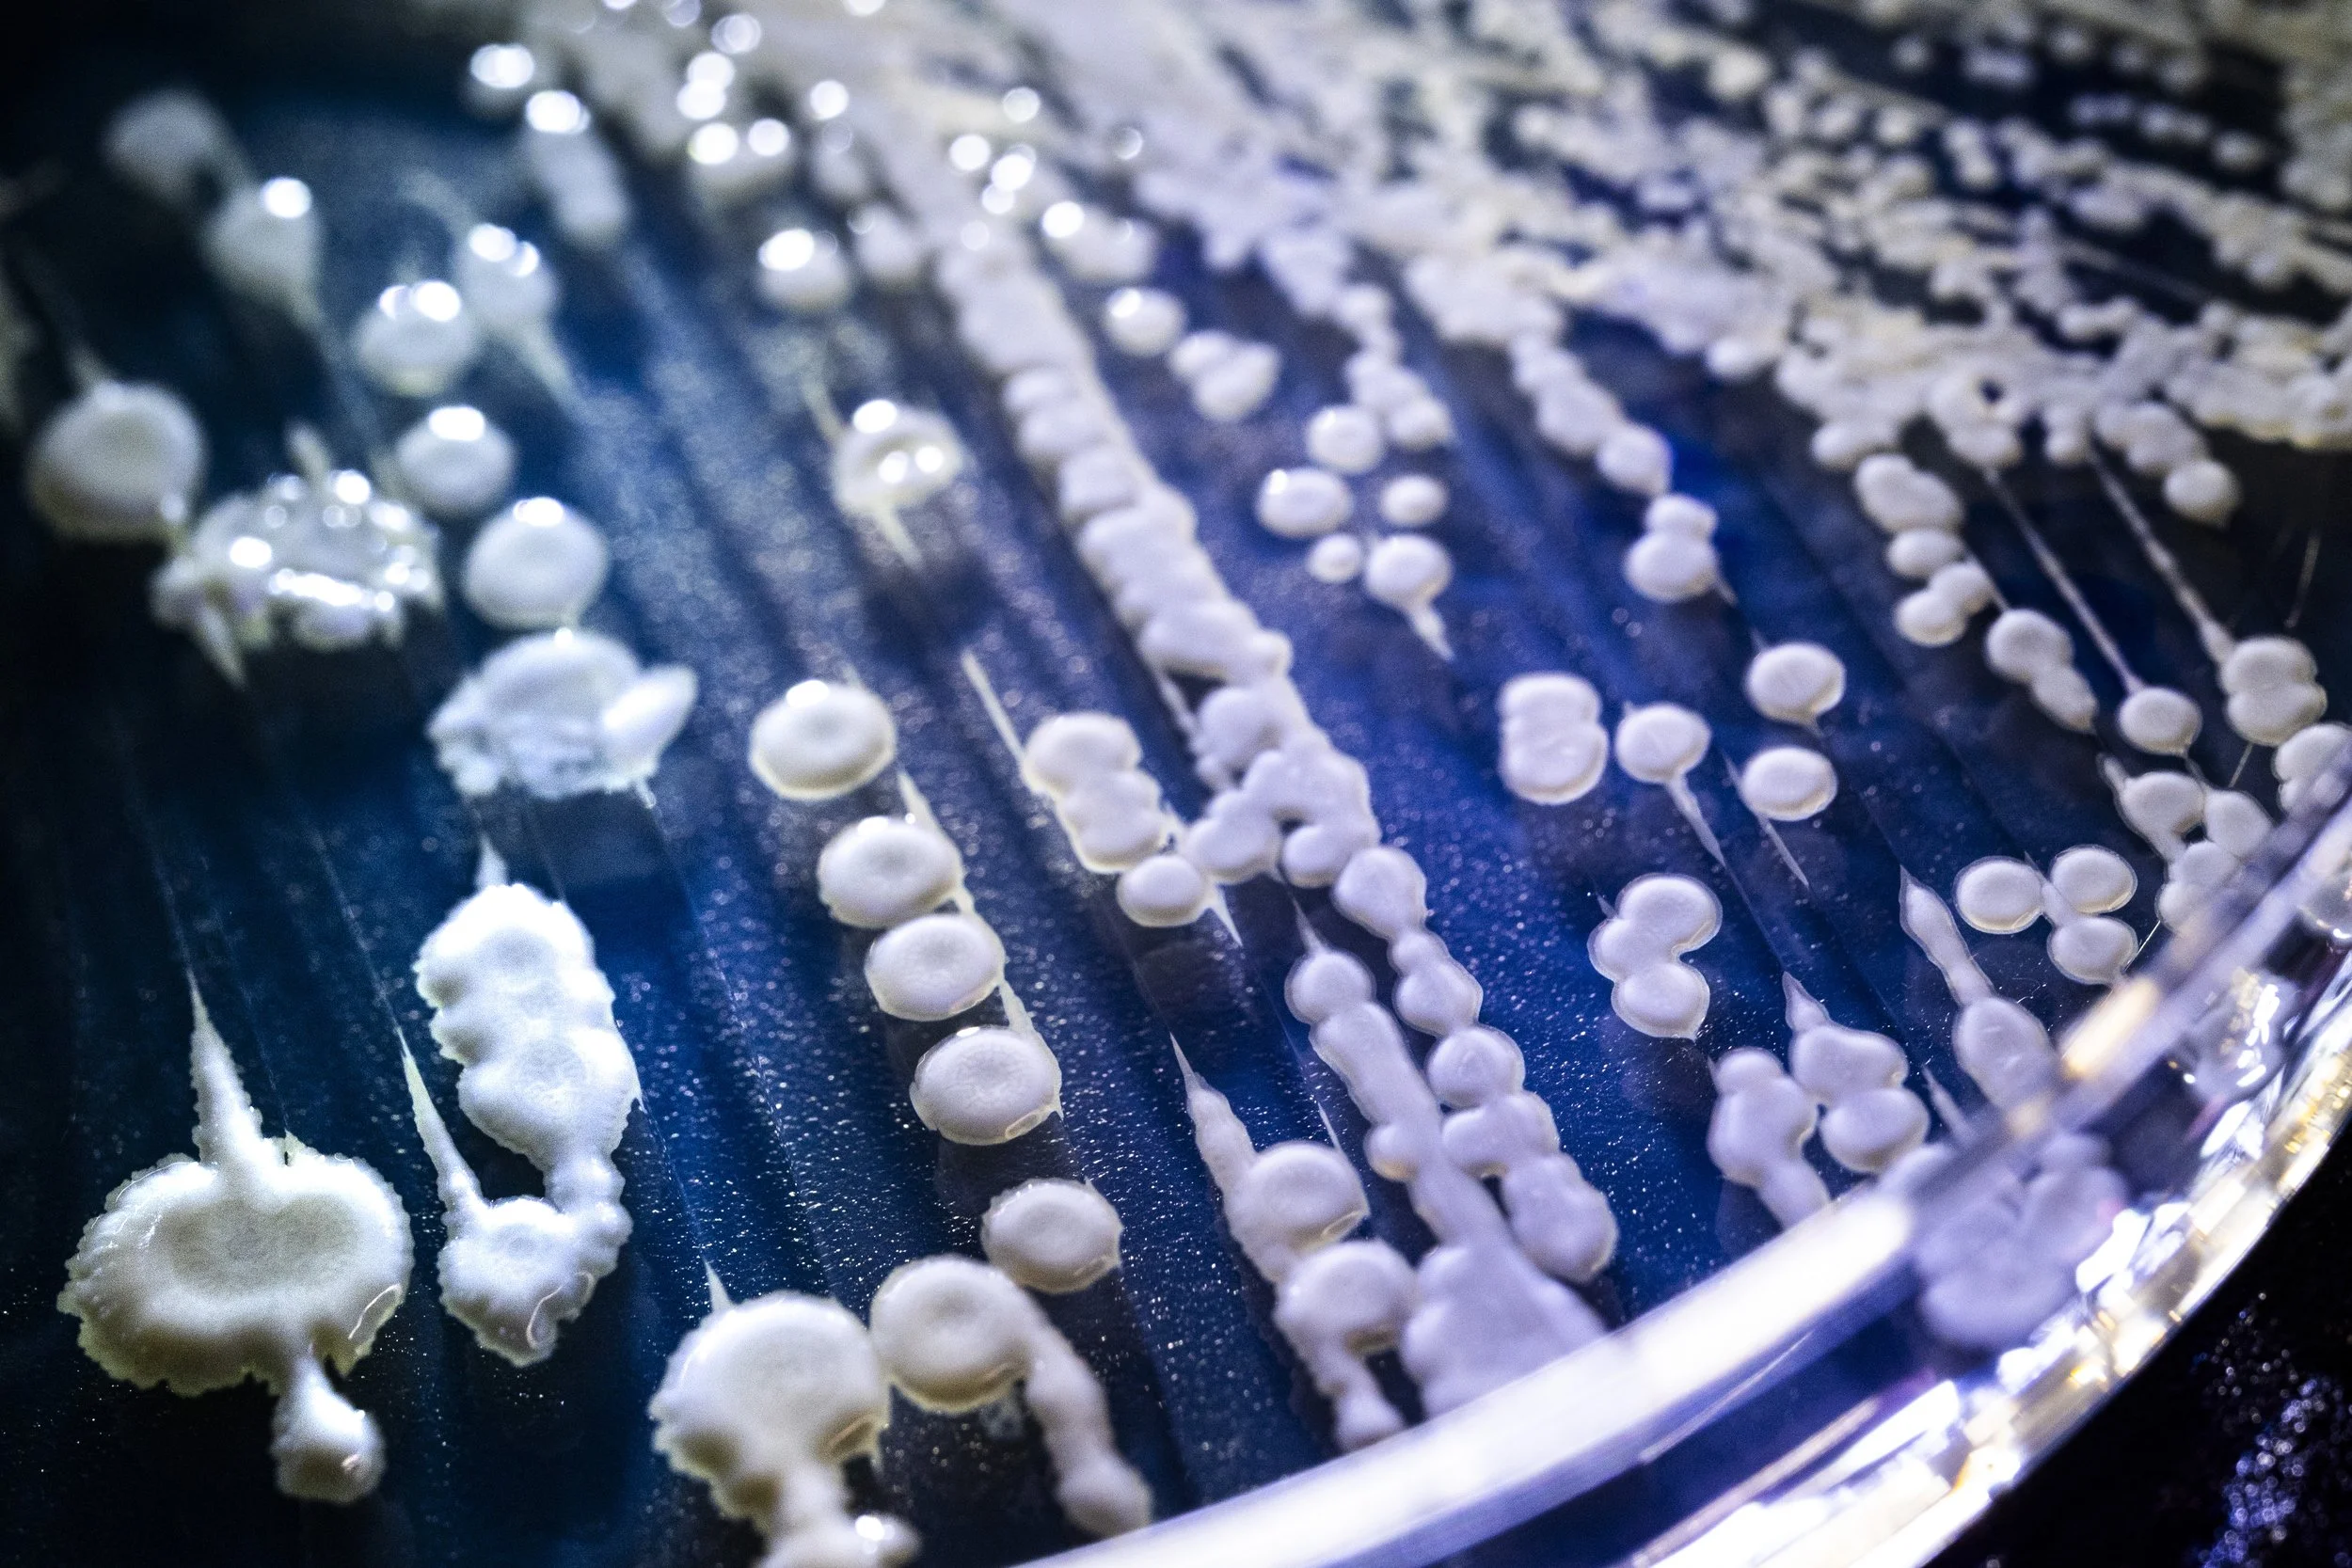

Boston Healthcare & Biotech Photographer
As a Boston-based healthcare photographer, I specialize in capturing imagery within biotech, pharmaceutical, and scientific environments. My work highlights innovation in labs and research spaces, showcasing the people and technology driving medical and biotech advancements. With experience photographing scientists, researchers, and healthcare professionals, I am able to capture authentic, high-quality visuals that help Boston’s leading healthcare and biotech companies tell their stories.